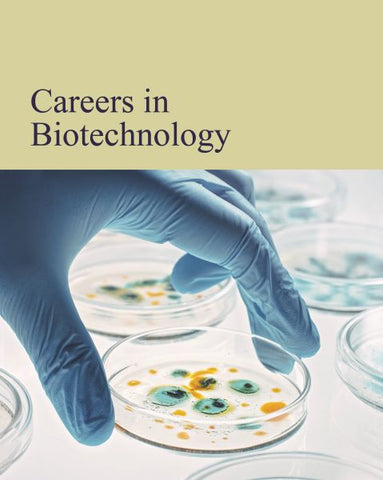

Careers in Engineering
$ 125.00
Broadly speaking, engineers design and build machines, structures, and systems. Its four main branches are chemical engineering, civil engineering, electrical engineering, and mechanical engineering. Other significant branches include aerospace engineering, marine engineering, and computer engineering, so students with a career in engineering in mind have a lot to consider when choosing their career path.

Share this item: